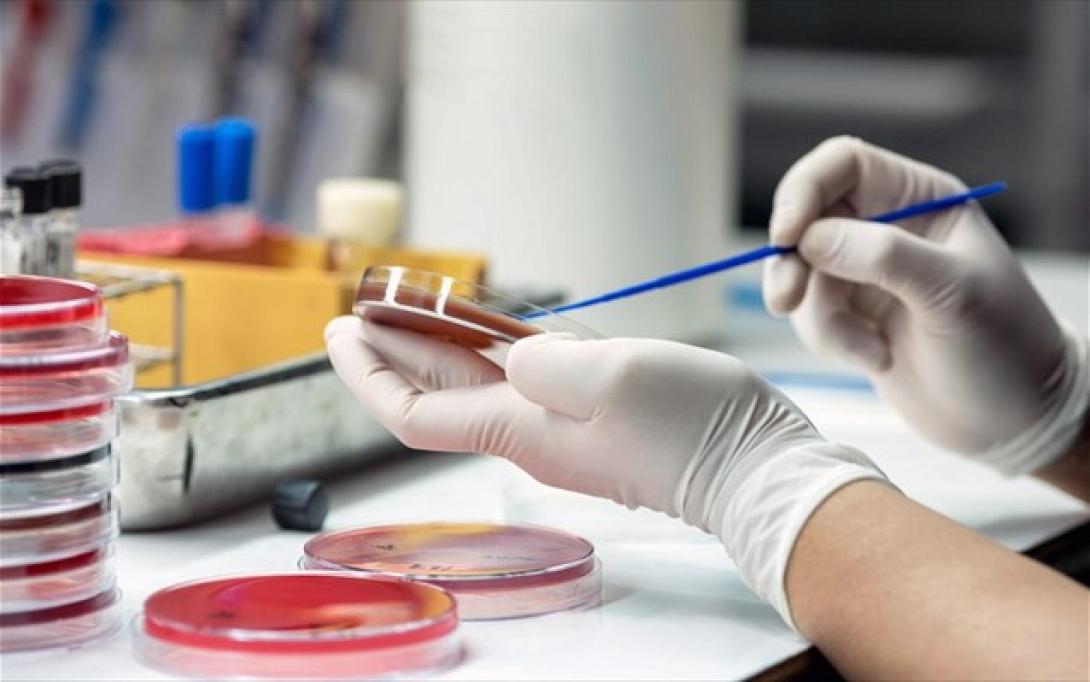
iatriki-ereuna-sipsi.jpg

Επιστήμονες στις ΗΠΑ ανέπτυξαν ένα νέο απλό τεστ, που είναι το πρώτο το οποίο μπορεί να διαγνώσει άμεσα τη σήψη από μία μόνο σταγόνα αίματος. Το τεστ είναι γρήγορο, φθηνό και ακριβές, ενώ μπορεί εύκολα να προσαρμοσθεί, ώστε να επιτρέπει την παρακολούθηση των ασθενών που κινδυνεύουν από σήψη.
Η σήψη είναι μια απειλητική για τη ζωή κατάσταση, κατά την οποία το σώμα αντιδρά με ακραίο τρόπο στη μόλυνση ιστών και οργάνων του. Περίπου ένας στους τέσσερις ασθενείς με σήψη πεθαίνει.
Σήμερα, υπάρχει αδυναμία στη διάγνωσή της σήψης σε ποσοστό 30% περίπου των ασθενών, καθώς τα υπάρχοντα τεστ είναι αργά (χρειάζονται μέρες για να βγάλουν αποτέλεσμα) και όχι ακριβή. Αυτό έχει ως συνέπεια συχνά η κατάλληλη θεραπεία να καθυστερεί, αυξάνοντας έτσι τον κίνδυνο θανάτου.
Έχει υπολογισθεί ότι για κάθε ώρα που καθυστερεί η διάγνωση της σήψης, ο κίνδυνος θανάτου του ασθενούς αυξάνεται κατά σχεδόν 8%. Συχνά επίσης οι ασθενείς -για προληπτικούς λόγους- παίρνουν περιττά αντιβιοτικά, πράγμα που σταδιακά ενισχύει την αντίσταση των μικροβίων στα αντιβιοτικά.
Οι ερευνητές, με επικεφαλής τον δρα Ντάνιελ Ιρίμια του Γενικού Νοσοκομείου της Μασαχουσέτης στη Βοστώνη, που έκαναν τη σχετική δημοσίευση στο περιοδικό βιοϊατρικής μηχανικής "Nature Biomedical Engineering", ανέπτυξαν μια μικροσυσκευή μικροροών (microfluidic) με διάμετρο μόνο πέντε χιλιοστών, η οποία δέχεται μια σταγόνα αίματος.
Η συσκευή καταγράφει την κίνηση των ουδετερόφιλων λευκών κυττάρων του αίματος, τα οποία δείχνουν την τυχόν ανεξέλεγκτη αντίδραση του ανοσοποιητικού συστήματος. Με τη βοήθεια ενός ειδικού αλγόριθμου μηχανικής μάθησης, αναλύονται διάφορες παράμετροι (αριθμός ουδετερόφιλων, χαρακτηριστικές κινήσεις τους ή διάρκεια ακινησίας κ.α.), που «προδίδουν» την παρουσία της σήψης.
Το τεστ βγάζει μέσα σε λίγες μόνο ώρες ένα «σκορ σήψης», ανάλογα με την αντίδραση του οργανισμού και τη σοβαρότητα του περιστατικού. Οι επιστήμονες δοκίμασαν το τεστ σε 42 άτομα από τα οποία είχε ληφθεί αίμα κατά την πρώτη μέρα εισαγωγής τους στο νοσοκομείο και έδειξαν ότι η νέα μέθοδος μπορεί να διακρίνει τους υγιείς, από όσους έχουν σήψη, με ακρίβεια και ευαισθησία άνω του 95%.
Το τεστ πρέπει να αξιολογηθεί σε μεγαλύτερο αριθμό ανθρώπων, προτού αξιοποιηθεί κλινικά. Ελπίζεται ότι στο μέλλον θα βελτιώσει την πιθανότητα επιβίωσης των ασθενών με υψηλό κίνδυνο σήψης και θα μειώσει παράλληλα την κατάχρηση των αντιβιοτικών.
Με μία σταγόνα αίματος το πρώτο απλό τεστ γρήγορης διάγνωσης της σήψης
Ακολουθήστε το ekriti.gr στο Google News και μάθετε πρώτοι όλες τις ειδήσεις για την Κρήτη και όχι μόνο.
ΡΟΗ ΕΙΔΗΣΕΩΝ











